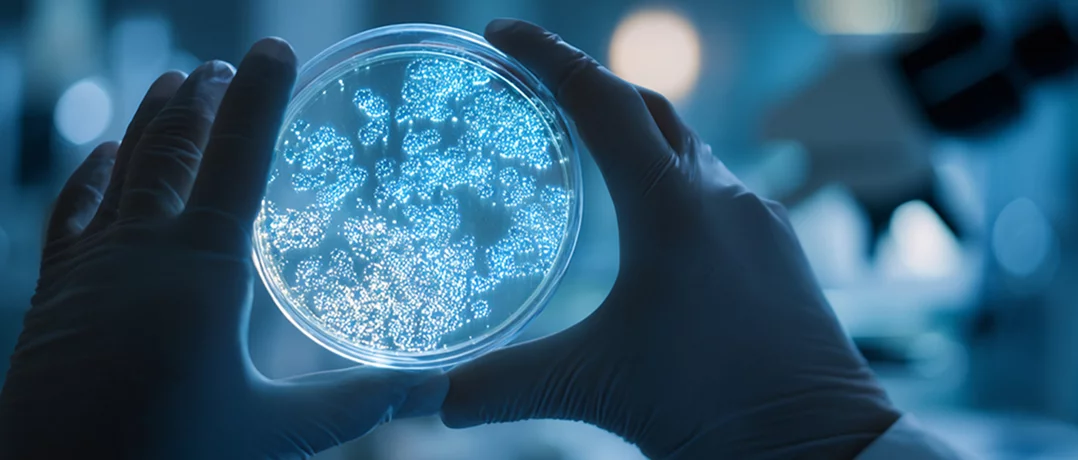
New gene discovery brings hope for treating cancer

Researchers have uncovered how defects in the WNT signaling pathway drive cancer growth through elevated NPM1 levels, opening the door to targeted therapies for hard-to-treat bowel and liver tumors.
New gene discovery brings hope for treating cancer
New gene discovery brings hope for treating cancer

A new genetic discovery may open the door to targeted treatments for some of the most challenging cancers to treat. A study published in “Nature Genetics” has identified a key protein involved in the growth of bowel cancer and certain types of liver cancer, offering renewed hope for therapies that could stop these tumors from growing.
The research centers on nucleophosmin (NPM1), a protein that plays a role in regulating cell growth. Scientists found that NPM1 appears at unusually high levels in cancerous tissues of the bowel and liver, an abnormality linked to a genetic defect in a critical cellular communication system known as the WNT signaling pathway.
How cancer hijacks the body’s growth signals
Under normal conditions, the WNT signaling pathway helps regulate when and where cells should grow, divide, or stop multiplying. It plays a vital role during development and tissue maintenance. However, when genetic defects disrupt this system, cancer cells can exploit it to grow uncontrollably.
The researchers discovered that flaws in the WNT pathway allow cancer cells to elevate NPM1 levels, effectively overriding the body’s natural growth limits and enabling tumor formation in specific tissues. This helps explain why certain genetic mutations lead to cancer in particular organs, such as the bowel and liver, rather than affecting the entire body.
Why NPM1 could be a promising target
One of the study’s most significant findings is that NPM1 does not appear to be essential for the normal functioning of healthy adult tissues. This makes it a particularly attractive target for treatment.
According to Professor Owen Sansom, the study’s lead researcher at the University of Glasgow, this opens up new therapeutic possibilities. “Because NPM1 is not required for the health of normal adult tissues, blocking it could be a safe way to treat certain cancers,” he explained. This includes forms of bowel and liver cancer that are often difficult to manage with existing therapies.
By inhibiting NPM1, scientists believe it may be possible to slow or even halt the growth of tumors driven by WNT pathway defects, without causing widespread damage to healthy cells.
A step toward more targeted cancer therapies
While further research and clinical trials are needed, the findings represent an important step toward more precise, gene-targeted cancer treatments. Rather than broadly attacking rapidly dividing cells, future therapies could focus on the specific molecular mechanisms that allow certain cancers to grow.
For patients with bowel and liver cancers linked to WNT signaling defects, this discovery could eventually translate into treatments that are not only more effective, but also safer. As scientists continue to unravel the genetic pathways behind cancer, studies like this highlight how understanding the biology of disease can lead to smarter, more targeted solutions.


